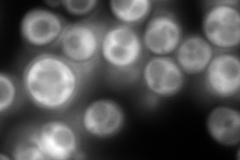
YNL209W
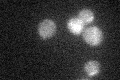
YNL209W

View description
Cytoplasmic ATPase that is a ribosome-associated molecular chaperone, functions with J-protein partner Zuo1p; may be involved in the folding of newly-synthesized polypeptide chains; member of the HSP70 family; homolog of SSB1
Localization:
Intensity:
Fold change:
Significance:
-
C’ GFP library in SD

below threshold18.35 -
N' NOP1pr-GFP in SD
cytosol837.351 -
N' TEF2pr-mCherry in SD

cell periphery,vacuole0 -
N' NATIVEpr-GFP in SD

cytosol658.386 -
N' TEF2pr-VC and Cyto-VN in SD

#N/A0 -
C’ GFP library in SD+DTT

cytosol18.090.98No -
C’ GFP library in SD+H2O2
cytosol18.481No -
C’ GFP library in Starvation Media

cytosol15.540.84No -
C’ GFP library on the background of Pup2-DaMP

below threshold -
C’ GFP library on the background of CCT mutant

below threshold23.13341.26004No
